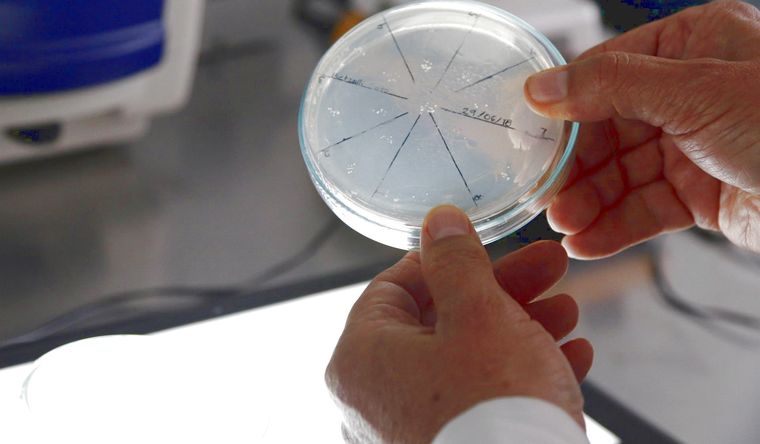
Las bacterias, objeto de estudio de científicos de USA. Foto: Efe.

Inaudito descubrimiento: las bacterias pueden almacenar recuerdos y los transmiten
Las bacterias son capaces de crear algo así como recuerdos sobre cuándo formar estrategias de infección y resistencia a los antibióticos, o enjambres para agruparse en una superficie, según una nueva investigación científica.
El descubrimiento, a cargo de investigadores de la Universidad de Texas en Austin, se relaciona con un elemento químico común que las células bacterianas pueden usar para formar y transmitir estos recuerdos a su progenie a lo largo de generaciones posteriores.
El hallazgo, que se publica en Proceedings of the National Academy of Sciences (PNAS), descubrió que la bacteria E. coli utiliza los niveles de hierro como una forma de almacenar información sobre diferentes comportamientos que luego pueden activarse en respuesta a ciertos estímulos.
Los científicos habían observado previamente que las bacterias que tenían una experiencia previa de enjambre (moviéndose sobre una superficie como colectivo usando flagelos) mejoran el rendimiento de enjambre posterior. El equipo de investigación se propuso descubrir por qué.
Las bacterias no tienen neuronas, sinapsis ni sistema nervioso, por lo que los recuerdos no son como los de apagar velas en una fiesta de cumpleaños infantil. Se parecen más a información almacenada en una computadora.
"Las bacterias no tienen cerebro, pero pueden recopilar información de su entorno, y si se han encontrado con ese entorno con frecuencia, pueden almacenar esa información y acceder rápidamente a ella más tarde para su beneficio", dijo en un comunicado Souvik Bhattacharyya, autor principal y científico becario en el Departamento de Biociencias Moleculares.
Todo vuelve al hierro, uno de los elementos más abundantes en la Tierra. Las bacterias singulares y flotantes tienen diferentes niveles de hierro. Los científicos observaron que las células bacterianas con niveles más bajos de hierro eran mejores enjambres. Por el contrario, las bacterias que formaban biopelículas, capas densas y pegajosas de bacterias sobre superficies sólidas, tenían altos niveles de hierro en sus células. Las bacterias con tolerancia a los antibióticos también tenían niveles equilibrados de hierro. Estos recuerdos de hierro persisten durante al menos cuatro generaciones y desaparecen en la séptima generación.
"Antes de que hubiera oxígeno en la atmósfera de la Tierra, la vida celular temprana utilizaba hierro para muchos procesos celulares. El hierro no sólo es fundamental en el origen de la vida en la Tierra, sino también en la evolución de la vida", dijo Bhattacharyya. "Tiene sentido que las células lo utilicen de esta manera".
Los investigadores teorizan que cuando los niveles de hierro son bajos, se activan memorias bacterianas para formar un enjambre migratorio de rápido movimiento en busca de hierro en el medio ambiente. Cuando los niveles de hierro son altos, los recuerdos indican que este entorno es un buen lugar para permanecer y formar una biopelícula.
"Los niveles de hierro son definitivamente un objetivo para la terapéutica porque el hierro es un factor importante en la virulencia", dijo Bhattacharyya. "En última instancia, cuanto más sabemos sobre el comportamiento de las bacterias, más fácil será combatirlas".
Video: cómo se realiza una investigación científica
Dpa, Pnas, Ucuenca, Youtube.





